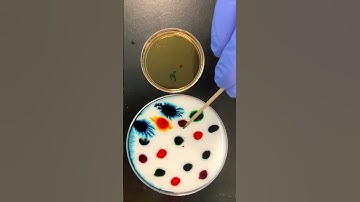
Fun in Science and Art #ShortsmasChallenge

⬇ DOWNLOAD NOW
Kalau muncul iklan pop-up, tutup lalu klik tombol kembali
Download lagu Mixing Methods: Art+Science at NCEAS secara gratis hanya untuk keperluan promosi. Dukung artis favorit kamu dengan membeli musik original di iTunes atau platform resmi lainnya.
 My daughter helped me "field test" a science experiment using food coloring to create art
My daughter helped me "field test" a science experiment using food coloring to create art
 The Science of Satisfying Color Mixing! #satisfying
The Science of Satisfying Color Mixing! #satisfying
Fun in Science and Art #ShortsmasChallenge
Fun in Science and Art #ShortsmasChallenge
 The Satisfying Science of Color Mixing! #relaxing
The Satisfying Science of Color Mixing! #relaxing
 The Science of Satisfying Color Mixing! #relaxing
The Science of Satisfying Color Mixing! #relaxing
 🎨The Science of Satisfying Color Mixing! #relaxing! #relaxing
🎨The Science of Satisfying Color Mixing! #relaxing! #relaxing
 The Science of Satisfying Color Mixing! #satisfying
The Science of Satisfying Color Mixing! #satisfying
 The Satisfying Science Behind Color Mixing! #relaxing
The Satisfying Science Behind Color Mixing! #relaxing